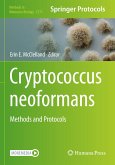

Gebundenes Buch
Methods and Protocols
2024
4. April 2024
Humana / Springer US / Springer, Berlin
978-1-0716-3821-7
eBook, PDF | 180,95 € |

Broschiertes Buch
Methods and Protocols
2. Aufl.
23. August 2023
Humana / Springer US / Springer, Berlin
978-1-0716-3360-1

Gebundenes Buch
Methods and Protocols
2. Aufl.
23. August 2023
Humana / Springer US / Springer, Berlin
978-1-0716-3357-1
eBook, PDF | 113,95 € |

Broschiertes Buch
Methods and Protocols
1st edition 2022
11. Februar 2022
Fundação Calouste Gulbenkian / Humana / Springer US / Springer, Berlin
978-1-0716-2037-3

Gebundenes Buch
Methods and Protocols
1st edition 2022
12. Februar 2022
Fundação Calouste Gulbenkian / Humana / Springer US / Springer, Berlin
978-1-0716-2034-2

Broschiertes Buch
2024
4. Oktober 2024
Humana / Springer US / Springer, Berlin
978-1-0716-3467-7

Broschiertes Buch
Methods and Protocols
28. Juli 2025
Humana / Springer US / Springer, Berlin
89510332,978-1-0716-4065-4

Gebundenes Buch
Methods and Protocols
29. September 2025
Humana / Springer US / Springer, Berlin
978-1-0716-4582-6
eBook, PDF | 153,95 € |

Broschiertes Buch
Methods and Protocols
2. Aufl.
24. Juli 2025
Humana / Springer US / Springer, Berlin
89507450,978-1-0716-4029-6

Broschiertes Buch
25. Juli 2025
Humana / Springer US / Springer, Berlin
89285645,978-1-0716-3760-9

Broschiertes Buch
Methods and Protocols
24. Juli 2025
Humana / Springer US / Springer, Berlin
89501226,978-1-0716-3928-3

Broschiertes Buch
Methods and Protocols
24. Juli 2025
Humana / Springer US / Springer, Berlin
89296223,978-1-0716-3884-2

Broschiertes Buch
26. Juli 2025
Humana / Springer US / Springer, Berlin
89501005,978-1-0716-3924-5

Broschiertes Buch
Methods and Protocols
2. Aufl.
24. Juni 2025
Humana / Springer US / Springer, Berlin
89295148,978-1-0716-3876-7
Broschiertes Buch
Methods and Protocols
18. Mai 2025
Humana / Springer US / Springer, Berlin
89283743,978-1-0716-3724-1
Ähnlichkeitssuche: Fact®Finder von OMIKRON